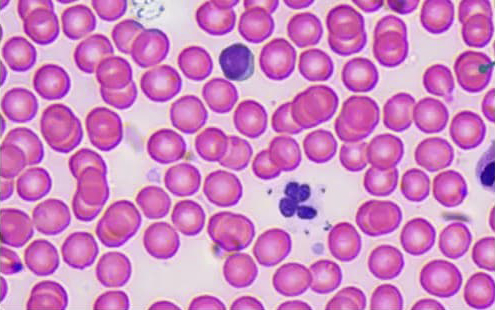
Beaverlab Darwin MX Pro

- Все товары
- Товары для дома
- Товары для детей
- Умный микроскоп с дисплеем Beaverlab Darwin MX Pro
Умный микроскоп с дисплеем Beaverlab Darwin MX Pro
-
Новинки | Скидки | Акции
Подписаться: @m_home.kz
- Через сайт - кнопка В корзину
- По телефону +7 775 007 06 25
- Через WhatsApp
- Через Instagram @m_home.kz
- Наличными в Алматы
- Картой на сайте
- Через приложение Каспи (Рассрочка и кредит)
Бесплатно
- По центру Алматы от 10 000 KZT
- По Казахстану от 30 000 KZT
При заказе на меньшую сумму - доставка платная подробнее
- 1 год на все электронные товары
- Возврат только неиспользованного либо бракованного товара
Описание товара
Умный микроскоп с дисплеем Beaverlab Darwin MX Pro
Исследования на уровне профессиональной техники

Увлекательная наука
Продвинутая конфигурация и удобный интерфейс умного микроскопа с дисплеем Beaverlab Darwin MX Pro помогают детям открывать удивительный микромир. Погружайтесь в исследования, чтобы расширить знания об окружающем мире и увлечь ребёнка наукой.

Изучение насекомых
Изучение клеток
Изучение
клеток

Изучение волокон

Изучение бактерий

Открывая невидимое
Линзы умного микроскопа Beaverlab Darwin MX Pro с особым покрытием обеспечивают кристально чёткое изображение без малейших искажений. Благодаря высокому коэффициенту увеличения и точной фокусировке вы сможете рассмотреть объекты микроскопических размеров и открыть удивительный мир, скрытый от невооружённого глаза.
Увеличение до
1600x

Увлекательная визуализация
Умный микроскоп Beaverlab Darwin MX Pro заменяет классический окуляр современным 2K IPS-дисплеем. Чувствительный сенсор Sony улавливает максимум света, передавая яркие, естественные цвета и создавая живое, реалистичное изображение. Исследовать микромир стало не только комфортно для глаз, но и по-настоящему увлекательно.
1200:1
контрастность
170°
угол обзора
Сенсорный
экран

Микроскоп будущего
Умный микроскоп Beaverlab Darwin MX Pro позволяет делать фото- и видеозаписи ваших наблюдений в высоком качестве. С помощью встроенного ИИ вы можете редактировать изображения, выделять детали, распознавать структуры и получать более точные данные.

Современные технологии
Умный микроскоп с дисплеем Beaverlab Darwin MX Pro оснащён современным энергоэффективным процессором, который обеспечивает плавную и стабильную работу. Встроенное хранилище eMMC подходит для хранения объёмных данных, а ёмкий аккумулятор в сочетании с зарядкой через Type-C гарантирует постоянную готовность к использованию.
4 ядра
Процессор
8 Гб
Хранилище
6000 мАч
Аккумулятор

Внимание к деталям
Защита объективов

Удобный регулятор

Подвижный столик

Настройка подсветки

Магнитные зажимы

Нескользящие опоры

Комплект поставки

Darwin MX Pro

Образцы

Зажимы

Кабель

Руководство


